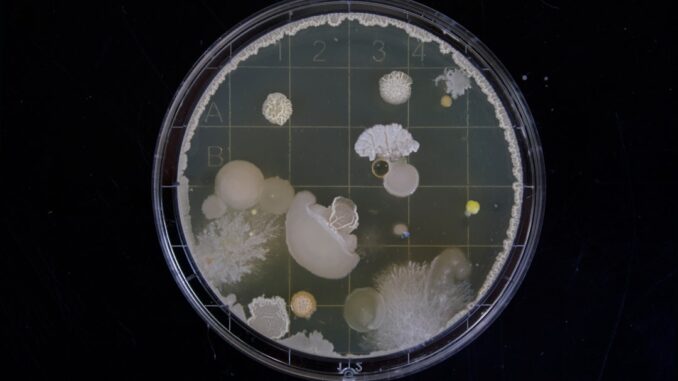

Abstract
Antibiotic resistance (AMR) represents one of the most pressing and multifaceted threats to global public health in the 21st century, fundamentally compromising the efficacy of treatments for a wide array of bacterial infectious diseases. This comprehensive report meticulously examines the intricate biological mechanisms by which bacteria develop and disseminate resistance, scrutinizes the current and evolving global landscape of multi-drug resistant organisms, assesses the profound health and economic impacts of this escalating crisis, and thoroughly explores the extensive, multi-sectoral strategies being collaboratively employed worldwide to combat this urgent issue. The objective is to provide an in-depth understanding of AMR, its drivers, consequences, and the concerted efforts required to mitigate its impact on human, animal, and environmental health.
Many thanks to our sponsor Esdebe who helped us prepare this research report.
1. Introduction
Antibiotic resistance is an inevitable evolutionary phenomenon where bacteria acquire mechanisms to withstand antimicrobial drugs designed to kill them or inhibit their growth. Since the dawn of the antibiotic era with Alexander Fleming’s discovery of penicillin in 1928 and its widespread clinical application in the 1940s, these ‘miracle drugs’ have revolutionized medicine, transforming once-fatal infections into treatable conditions. However, the very success of antibiotics inadvertently fueled the selective pressure for resistance. The widespread, often inappropriate, use of antibiotics in human medicine, animal agriculture, and environmental settings has accelerated the natural evolutionary processes, leading to the emergence and rapid dissemination of resistant bacterial strains across the globe.
This phenomenon undermines the effectiveness of existing antibiotics, leading to a cascade of detrimental outcomes: prolonged illnesses, increased hospital stays, higher healthcare costs, and, critically, elevated mortality rates. The necessity to resort to ‘last-resort’ or more potent and often more toxic medications, which may also be less effective, becomes increasingly frequent. The emergence of multi-drug resistant organisms (MDROs), commonly referred to as ‘superbugs,’ which are resistant to multiple classes of antibiotics, has escalated the urgency to address AMR through multifaceted and globally coordinated approaches. Without effective antibiotics, many routine medical procedures, such as complex surgeries, organ transplantation, and cancer chemotherapy, become far riskier, potentially returning medicine to a pre-antibiotic era. This report endeavors to provide a detailed exposition of AMR, spanning its molecular underpinnings to its global societal implications and the comprehensive strategies marshaled to confront it.
Many thanks to our sponsor Esdebe who helped us prepare this research report.
2. Biological Mechanisms of Antibiotic Resistance
Understanding the biological and genetic mechanisms underlying antibiotic resistance is paramount for developing effective diagnostic tools, novel antimicrobial agents, and targeted countermeasures. Bacteria have evolved an impressive arsenal of strategies to evade the effects of antibiotics, which can be broadly categorized into intrinsic resistance (inherent properties of a bacterium) and acquired resistance (gained through mutation or horizontal gene transfer).
2.1. Enzymatic Degradation or Modification
One of the most widespread and clinically significant mechanisms of resistance involves the production of bacterial enzymes that chemically inactivate or modify antibiotics, rendering them ineffective. These enzymes act by altering the antibiotic molecule such that it can no longer bind to its target or exert its inhibitory effect.
2.1.1. Beta-Lactamases
The most prominent example is the family of β-lactamases, enzymes produced predominantly by Gram-negative bacteria, but also by some Gram-positive species. These enzymes hydrolyze the crucial β-lactam ring present in penicillins, cephalosporins, monobactams, and carbapenems, thereby neutralizing their antibacterial properties. The diversity of β-lactamases is vast and continues to expand, posing a persistent challenge to clinical practice.
- Broad-spectrum β-lactamases: These enzymes hydrolyze penicillins and early-generation cephalosporins. Examples include TEM-1 and SHV-1, which are widespread in Escherichia coli and Klebsiella pneumoniae.
- Extended-spectrum β-lactamases (ESBLs): ESBLs represent a significant clinical concern as they are capable of hydrolyzing extended-spectrum cephalosporins (e.g., ceftriaxone, ceftazidime) and monobactams (e.g., aztreonam) but are inhibited by β-lactamase inhibitors like clavulanate. Common ESBL types include CTX-M, SHV, and TEM variants, often found in Enterobacteriaceae. Patients infected with ESBL-producing bacteria require carbapenems, which were once considered last-resort antibiotics.
- AmpC β-lactamases: These are typically chromosomal but can also be plasmid-mediated. They confer resistance to penicillins, cephalosporins (including third-generation), and monobactams. Unlike ESBLs, AmpC β-lactamases are not inhibited by clavulanate. They are commonly found in Enterobacter, Serratia, and Pseudomonas aeruginosa.
- Carbapenemases: These are the most alarming group of β-lactamases, as they can hydrolyze carbapenems (e.g., imipenem, meropenem, ertapenem), which are critical last-line antibiotics for treating severe bacterial infections. Carbapenemases confer resistance to nearly all β-lactams. Major classes include:
- KPC ( Klebsiella pneumoniae Carbapenemase): Serine carbapenemases prevalent globally, primarily in Klebsiella pneumoniae but also in other Enterobacteriaceae.
- NDM (New Delhi Metallo-β-lactamase): Metallo-β-lactamases (MBLs) requiring zinc for activity. NDM-1 was first identified in India and has since spread worldwide, rendering bacteria resistant to almost all β-lactams, including carbapenems, but not aztreonam. MBLs are not inhibited by existing β-lactamase inhibitors.
- OXA-48-like carbapenemases: Class D carbapenemases often found in Enterobacteriaceae, particularly Klebsiella pneumoniae.
- VIM and IMP: Other important MBLs with global dissemination.
2.1.2. Aminoglycoside Modifying Enzymes
Bacteria can produce enzymes that chemically modify aminoglycosides (e.g., gentamicin, tobramycin, amikacin) by acetylation, phosphorylation, or adenylylation. These modifications prevent the aminoglycoside from binding to its target site on the bacterial ribosome, thereby abolishing its inhibitory effect. Examples include aminoglycoside acetyltransferases (AAC), phosphotransferases (APH), and nucleotidyltransferases (ANT). These enzymes are widespread in various Gram-negative and Gram-positive pathogens.
2.1.3. Chloramphenicol Acetyltransferases
These enzymes acetylate chloramphenicol, a bacteriostatic antibiotic, preventing it from binding to the 50S ribosomal subunit and inhibiting protein synthesis. While chloramphenicol use has declined in many regions due to toxicity concerns, resistance genes remain prevalent.
2.2. Alteration of Target Sites
Bacteria can develop resistance by modifying the cellular component that an antibiotic targets, reducing the drug’s affinity or preventing its binding altogether. This mechanism typically arises from spontaneous mutations in chromosomal genes or the acquisition of new genetic material.
2.2.1. Methicillin-Resistant Staphylococcus aureus (MRSA)
MRSA is a prime example of target alteration. Methicillin and other β-lactam antibiotics normally bind to penicillin-binding proteins (PBPs), essential enzymes involved in bacterial cell wall synthesis. MRSA acquires the mecA gene (or variants like mecC), which encodes for a novel PBP, PBP2a (or PBP2c). PBP2a has a very low affinity for β-lactam antibiotics, allowing cell wall synthesis to proceed unimpeded even in the presence of these drugs. This renders MRSA resistant to virtually all β-lactam antibiotics, except for certain newer agents with specific activity against PBP2a.
2.2.2. Vancomycin-Resistant Enterococci (VRE)
Vancomycin is a glycopeptide antibiotic that inhibits cell wall synthesis by binding to the D-Ala-D-Ala termini of peptidoglycan precursors. Enterococci, particularly Enterococcus faecium and Enterococcus faecalis, can acquire genes (e.g., vanA, vanB) that modify the peptidoglycan precursor from D-Ala-D-Ala to D-Ala-D-Lac (D-lactate) or D-Ala-D-Ser (D-serine). This modification reduces vancomycin’s binding affinity by approximately 1,000-fold, conferring high-level resistance. VRE infections are particularly challenging to treat, especially in immunocompromised patients.
2.2.3. Fluoroquinolone Resistance
Fluoroquinolones target bacterial DNA gyrase and topoisomerase IV, enzymes crucial for DNA replication, transcription, and repair. Resistance often develops through point mutations in the genes encoding these enzymes (e.g., gyrA, gyrB, parC, parE), leading to structural changes that prevent the fluoroquinolone from binding effectively. Additionally, plasmid-mediated quinolone resistance (PMQR) genes can provide low-level resistance, often through efflux pumps or enzyme production, which facilitates the selection of higher-level chromosomal resistance.
2.2.4. Rifampicin Resistance
Rifampicin targets the bacterial RNA polymerase, inhibiting RNA synthesis. Resistance typically arises from point mutations in the rpoB gene, which encodes the β-subunit of RNA polymerase. These mutations alter the binding site for rifampicin, a critical first-line drug for tuberculosis treatment. The prevalence of multidrug-resistant tuberculosis (MDR-TB), defined as resistance to both rifampicin and isoniazid, highlights the severity of this mechanism.
2.2.5. Macrolide, Lincosamide, and Streptogramin B (MLSB) Resistance
This broad resistance mechanism, particularly common in Gram-positive bacteria like Staphylococcus aureus and Streptococcus pneumoniae, involves methylation of a specific adenine residue in the 23S ribosomal RNA. This modification prevents macrolides (e.g., erythromycin, azithromycin), lincosamides (e.g., clindamycin), and streptogramin B from binding to the 50S ribosomal subunit and inhibiting protein synthesis. The genes encoding methyltransferases (e.g., erm genes) are often plasmid-mediated and can be inducible or constitutive.
2.3. Reduced Permeability
For an antibiotic to be effective, it must reach its intracellular target in sufficient concentrations. Bacteria, particularly Gram-negative species with their complex outer membrane, can reduce antibiotic uptake, thereby lowering the effective intracellular drug concentration.
Gram-negative bacteria possess an outer membrane that acts as a selective barrier, regulating the passage of molecules through specialized protein channels called porins. Alterations in the number, type, or structure of these porin channels can significantly decrease antibiotic entry. For instance, in Pseudomonas aeruginosa and Enterobacteriaceae, mutations or transcriptional down-regulation of major porin genes (e.g., OmpC, OmpF in E. coli; OprD in P. aeruginosa for carbapenems) can prevent antibiotics, especially hydrophilic ones like β-lactams and fluoroquinolones, from reaching their targets. This mechanism often acts synergistically with efflux pumps to confer higher levels of resistance.
Furthermore, modifications to the lipopolysaccharide (LPS) components of the outer membrane can alter its charge or hydrophobicity, affecting the diffusion of certain antibiotics and increasing resistance to cationic antimicrobial peptides and polymyxins.
2.4. Efflux Pumps
Efflux pumps are transmembrane protein complexes that actively expel antibiotics and other toxic compounds from the bacterial cell, maintaining intracellular drug concentrations below inhibitory levels. These pumps are ubiquitous in bacteria and can be either chromosomally encoded or plasmid-mediated.
Bacteria possess several families of efflux pumps, including the Resistance-Nodulation-Cell Division (RND) family, Major Facilitator Superfamily (MFS), Small Multidrug Resistance (SMR) family, ATP-binding cassette (ABC) family, and Multidrug and Toxin Extrusion (MATE) family. Many efflux pumps are broad-spectrum, capable of expelling multiple classes of antibiotics, thus contributing to multidrug resistance. For example:
- The AcrAB-TolC system in Enterobacteriaceae (e.g., E. coli, Salmonella) is a well-characterized RND efflux pump that actively extrudes a wide range of antibiotics, including β-lactams, fluoroquinolones, tetracyclines, and macrolides. Its overexpression is a common cause of resistance in clinical isolates.
- The MexAB-OprM and MexXY-OprM systems in Pseudomonas aeruginosa are also RND-type efflux pumps that confer resistance to multiple antibiotic classes, including carbapenems, fluoroquinolides, and aminoglycosides. These pumps contribute significantly to the intrinsic and acquired resistance of P. aeruginosa, a notoriously difficult-to-treat pathogen.
The expression of efflux pumps is often tightly regulated by environmental signals and can be upregulated under antibiotic stress, forming an adaptive response to drug presence.
2.5. Horizontal Gene Transfer (HGT)
While spontaneous mutations contribute to resistance, the rapid and widespread dissemination of resistance genes within and between bacterial species is primarily facilitated by horizontal gene transfer (HGT). HGT mechanisms allow bacteria to acquire genetic material, including antibiotic resistance genes (ARGs), from other bacteria, accelerating the evolution and spread of resistance far more effectively than vertical (parent-to-offspring) transmission alone.
2.5.1. Conjugation
Conjugation is the direct transfer of genetic material (usually plasmids) from one bacterial cell to another through cell-to-cell contact. Plasmids are extrachromosomal, self-replicating DNA molecules that often carry multiple ARGs, forming ‘resistance plasmids’ or R-plasmids. A donor bacterium with a conjugative plasmid forms a pilus that connects to a recipient bacterium, and a copy of the plasmid DNA is transferred. This mechanism is highly efficient and can occur between different bacterial species, facilitating the rapid spread of multidrug resistance in diverse bacterial populations. Conjugative transposons are another form of mobile genetic elements that can move between bacterial chromosomes or plasmids, often carrying ARGs.
2.5.2. Transformation
Transformation involves the uptake of ‘naked’ DNA from the external environment by a recipient bacterial cell. Some bacteria are naturally ‘competent,’ meaning they can actively bind and internalize exogenous DNA. When a resistant bacterium dies, its DNA can be released into the environment, and fragments containing ARGs can be taken up and integrated into the genome of a competent susceptible bacterium. This mechanism is particularly important in pathogens like Streptococcus pneumoniae and Neisseria gonorrhoeae.
2.5.3. Transduction
Transduction involves the transfer of bacterial DNA by bacteriophages (viruses that infect bacteria). During the lytic cycle, a phage replicates within a bacterial cell, sometimes mistakenly packaging bacterial chromosomal DNA or plasmid DNA into new phage particles. When these ‘transducing phages’ infect a new bacterial cell, they inject the bacterial DNA, which can then integrate into the recipient’s genome, conferring new traits, including antibiotic resistance. Both generalized (any part of the bacterial genome) and specialized (specific parts) transduction can mediate ARG transfer.
2.5.4. Integrons and Transposons
These mobile genetic elements play a crucial role in capturing, expressing, and disseminating ARGs. Integrons are genetic platforms that can acquire gene cassettes (often containing ARGs) and express them. Transposons are ‘jumping genes’ that can move between DNA molecules (e.g., from plasmid to chromosome or vice versa), often carrying ARGs as cargo. The synergistic action of these elements within plasmids and chromosomes allows for the rapid assembly and spread of multidrug resistance gene cassettes.
2.6. Biofilm Formation
Bacteria in biofilms, sessile communities encased in a self-produced extracellular polymeric substance, exhibit significantly enhanced resistance to antibiotics compared to their planktonic (free-floating) counterparts. Biofilms contribute to resistance through multiple mechanisms:
- Physical Barrier: The biofilm matrix can impede the penetration of antibiotics, slowing their diffusion to deeper layers of the bacterial community.
- Altered Physiology: Bacteria within biofilms often adopt a slow-growing or quiescent metabolic state, making them less susceptible to antibiotics that primarily target actively dividing cells (e.g., β-lactams).
- Stress Response: Biofilm bacteria activate stress response pathways that can upregulate resistance mechanisms, such as efflux pumps.
- Horizontal Gene Transfer: The close proximity of bacteria within a biofilm facilitates HGT, allowing for efficient exchange of resistance genes.
Biofilm-associated infections are particularly challenging to treat and are common in chronic infections, medical device-related infections (catheters, prosthetics), and cystic fibrosis lungs.
2.7. Persister Cells
Persister cells are a small subpopulation of bacterial cells that, while genetically identical to the susceptible majority, enter a dormant, non-dividing state and are phenotypically tolerant to high concentrations of antibiotics. They do not carry resistance genes but survive antibiotic treatment by temporarily shutting down metabolic processes targeted by the drugs. Once the antibiotic selective pressure is removed, persister cells can revert to a normal growing state and repopulate the infection site, leading to relapsing infections. This phenomenon is distinct from genetic resistance but contributes significantly to treatment failure and the difficulty in eradicating chronic infections.
Many thanks to our sponsor Esdebe who helped us prepare this research report.
3. Global Landscape of Multi-Drug Resistant Organisms
The prevalence and patterns of multi-drug resistant organisms (MDROs) vary dramatically across the globe, influenced by a complex interplay of factors including antibiotic consumption rates, infection control practices, healthcare infrastructure, and socioeconomic conditions. The ‘One Health’ perspective recognizes that AMR is a problem interconnected across humans, animals, and the environment.
3.1. Key Resistant Pathogens and Syndromes
The World Health Organization (WHO) and other global health bodies have identified critical priority pathogens for which new antibiotics are urgently needed. These ‘superbugs’ represent some of the most significant threats to public health:
3.1.1. Carbapenem-Resistant Enterobacteriaceae (CRE)
CRE, which include species like Klebsiella pneumoniae, Escherichia coli, and Enterobacter species, are resistant to carbapenems – a class of antibiotics often reserved for severe infections. CRE can cause bloodstream infections, pneumonia, urinary tract infections, and wound infections, often with high mortality rates. The primary mechanism is the production of carbapenemases (e.g., KPC, NDM, OXA-48), which can rapidly spread via plasmids. The global spread of CRE, particularly in healthcare settings, poses a severe challenge, with limited treatment options often involving toxic last-line agents or combination therapies. The Centers for Disease Control and Prevention (CDC) has classified CRE as an ‘urgent threat’ due to their high mortality and rapid spread potential (CDC, 2019).
3.1.2. Methicillin-Resistant Staphylococcus aureus (MRSA)
MRSA remains a leading cause of hospital-acquired infections (HAIs) and is increasingly prevalent in community settings (CA-MRSA). It causes a range of infections from skin and soft tissue infections to life-threatening sepsis and pneumonia. Resistance is primarily due to the mecA gene encoding PBP2a. While vancomycin remains a primary treatment for severe MRSA infections, the emergence of vancomycin-intermediate S. aureus (VISA) and vancomycin-resistant S. aureus (VRSA) is a growing concern, limiting treatment options further (European Centre for Disease Prevention and Control, 2020).
3.1.3. Vancomycin-Resistant Enterococci (VRE)
VRE, primarily Enterococcus faecium and Enterococcus faecalis, cause HAIs, particularly in immunocompromised patients, leading to urinary tract infections, bloodstream infections, and endocarditis. VRE is often multidrug-resistant, making treatment challenging. The vanA and vanB genes, which confer vancomycin resistance, are frequently plasmid-borne, facilitating their spread.
3.1.4. Multidrug-Resistant (MDR) Pseudomonas aeruginosa
P. aeruginosa is an opportunistic pathogen known for its intrinsic and acquired resistance mechanisms, including efflux pumps, porin mutations, and β-lactamases (including carbapenemases). It causes severe infections in hospitalized and immunocompromised patients, such as ventilator-associated pneumonia, bloodstream infections, and infections in burn victims. Treating MDR P. aeruginosa often requires complex combination therapies or novel agents, many of which have significant toxicities (Navarrete-Campos et al., 2021).
3.1.5. Extensively Drug-Resistant (XDR) and Pan-Drug-Resistant (PDR) Acinetobacter baumannii
A. baumannii is a notorious nosocomial pathogen, often causing infections in critically ill patients, particularly in intensive care units. It is highly adept at acquiring resistance genes, leading to strains resistant to nearly all available antibiotics (XDR) or even all tested antibiotics (PDR). Treatment options for PDR A. baumannii are extremely limited, often necessitating investigational drugs or highly toxic agents like colistin, which is itself facing increasing resistance (Reuters, 2024).
3.1.6. Drug-Resistant Neisseria gonorrhoeae
N. gonorrhoeae, the causative agent of gonorrhea, has progressively developed resistance to multiple classes of antibiotics, including sulfonamides, penicillin, tetracyclines, and fluoroquinolones. More recently, strains showing reduced susceptibility or resistance to extended-spectrum cephalosporins (like ceftriaxone) and azithromycin have emerged. This raises concerns about untreatable gonorrhea, which could lead to increased morbidity, including infertility, ectopic pregnancy, and enhanced HIV transmission. The WHO has identified drug-resistant gonorrhea as a high-priority threat (WHO, 2017).
3.1.7. Drug-Resistant Mycobacterium tuberculosis (MDR-TB and XDR-TB)
Tuberculosis remains a major global health challenge. Multidrug-resistant TB (MDR-TB) is defined as resistance to at least isoniazid and rifampicin, the two most potent first-line anti-TB drugs. Extensively drug-resistant TB (XDR-TB) is MDR-TB with additional resistance to any fluoroquinolone and at least one of the three injectable second-line drugs (amikacin, kanamycin, capreomycin). These forms of TB are much harder and longer to treat, with lower success rates and higher mortality. The spread of drug-resistant TB is a major concern, particularly in regions with high TB burdens and weak health systems (WHO, 2023).
3.2. Geographic Hotspots and Driving Factors
AMR is a global problem, but its prevalence and specific resistance patterns exhibit significant geographical variations. Studies indicate that regions with high antibiotic consumption and limited infection control measures, particularly in South Asia and parts of Africa, report elevated rates of AMR (The Global Antibiotics Resistance Foundation, n.d.).
- South Asia: Countries like India have extremely high rates of resistance, especially to carbapenems in Enterobacteriaceae (e.g., NDM-1). This is attributed to widespread over-the-counter antibiotic availability, poor sanitation, high population density, and extensive use in agriculture.
- Africa: Resistance to first-line treatments for some bloodstream infections in Africa has surpassed 70%, raising alarm (Reuters, 2025). Limited diagnostic capabilities, irregular drug supply chains, and high prevalence of infectious diseases contribute to the problem.
- Southeastern Europe and Mediterranean: High rates of ESBL-producing Enterobacteriaceae and carbapenem-resistant Acinetobacter baumannii are frequently reported, linked to healthcare-associated outbreaks and varying infection control standards.
- Latin America: A mixed picture, with pockets of high resistance, particularly for MRSA and carbapenemase-producing Gram-negatives, influenced by diverse healthcare systems and antibiotic access.
- High-Income Countries: While generally having better surveillance and stewardship programs, these countries still face significant challenges from MDROs, particularly in healthcare settings, due to international travel, globalization, and persistent challenges in infection control.
Driving factors for these hotspots include:
– Inappropriate antibiotic use: Over-prescription, self-medication, incomplete courses, and use for viral infections.
– Poor sanitation and hygiene: Facilitates the spread of resistant bacteria through contaminated food, water, and direct contact.
– Weak healthcare infrastructure: Lack of diagnostic facilities, inadequate infection prevention and control, and insufficient surveillance.
– Poverty and conflict: Disruption of healthcare services, displacement of populations, and limited access to clean water and sanitation.
– Lack of regulation: Uncontrolled sale of antibiotics without prescription and insufficient oversight of manufacturing and waste disposal.
3.3. ‘One Health’ Dimension
The ‘One Health’ approach acknowledges that human health is inextricably linked to animal health and the environment. This holistic perspective is crucial for understanding and addressing AMR:
3.3.1. Antibiotic Use in Livestock and Aquaculture
Globally, a significant proportion of antibiotics are used in animal agriculture, not only for treating sick animals but also for prophylaxis and, historically, as growth promoters. This widespread use creates selective pressure, leading to the development of resistant bacteria in animals. These resistant bacteria or their resistance genes can then spread to humans through:
- Food chain: Contaminated meat, poultry, or fish consumed by humans.
- Direct contact: Farmers, veterinarians, and slaughterhouse workers can acquire resistant bacteria from animals.
- Environmental dissemination: Manure used as fertilizer can spread resistant bacteria and ARGs to soil and water, which can then enter the human food chain or water supply (Van Boeckel et al., 2015).
3.3.2. Environmental Reservoirs of Resistance
The environment serves as a vast reservoir for ARGs and resistant bacteria. Sources include:
- Wastewater: Effluents from hospitals, pharmaceutical manufacturing plants, and municipal sewage contain antibiotics, resistant bacteria, and ARGs, which are then discharged into rivers, lakes, and oceans.
- Soil: Agricultural run-off, animal manure, and human waste introduce ARGs into soil ecosystems.
- Wildlife: Wild animals can carry resistant bacteria, potentially acting as vectors for their spread.
These environmental niches facilitate HGT between diverse bacterial populations, allowing ARGs to transfer to human pathogens. For example, urban wastewater has been identified as a significant melting pot for resistance evolution and dissemination (Rizzo et al., 2013).
3.3.3. Global Travel and Trade
International travel and trade act as potent vectors for the rapid global dissemination of resistant bacteria and ARGs. A resistant strain emerging in one part of the world can quickly be transported across continents by asymptomatic carriers or contaminated goods, establishing new outbreaks far from its origin (Kennedy et al., 2017).
Many thanks to our sponsor Esdebe who helped us prepare this research report.
4. Health and Economic Impacts of Antibiotic Resistance
The consequences of escalating AMR are profound, extending beyond individual patient outcomes to severely impact healthcare systems, global economies, and societal well-being. The crisis threatens to reverse decades of progress in modern medicine, making common infections untreatable and jeopardizing complex medical procedures.
4.1. Health Impacts
AMR directly leads to a myriad of adverse health outcomes, increasing morbidity and mortality worldwide.
4.1.1. Increased Morbidity and Mortality
Infections caused by resistant bacteria are inherently more challenging to treat. They often require the use of less effective, more toxic, or more expensive antibiotics, leading to prolonged illness, higher rates of complications, and increased risk of death. A seminal study published in The Lancet warns that antimicrobial resistant pathogens could be directly responsible for killing more than 39 million people by 2050, with an estimated 169 million deaths associated with drug-resistant infections by that year, underscoring the catastrophic potential (Time, 2024). For instance, bloodstream infections, pneumonia, and urinary tract infections caused by resistant bacteria have significantly higher mortality rates than their susceptible counterparts (O’Neill Report, 2016).
4.1.2. Longer Hospital Stays and Higher Treatment Complexity
Patients with resistant infections typically experience longer hospital stays, often requiring admission to intensive care units (ICUs). The need for multiple rounds of empirical or tailored antibiotic regimens, combined with extended diagnostic periods to identify the specific resistant pathogen, contributes to this. This protracted treatment places a significant burden on healthcare resources, leading to bed shortages and diversion of staff from other critical areas. Furthermore, the limited treatment options for extensively drug-resistant infections mean that healthcare providers often have to use drugs with a higher risk of adverse effects, further complicating patient management.
4.1.3. Jeopardy to Modern Medicine
Effective antibiotics are the bedrock of modern medicine. Their failure poses an existential threat to many routine, yet life-saving, medical interventions:
- Routine Surgeries: Procedures like hip replacements, appendectomies, and C-sections rely heavily on prophylactic antibiotics to prevent postoperative infections. Without effective protection, the risk of serious complications would soar.
- Organ Transplantation and Cancer Chemotherapy: Immunosuppressive therapies for these conditions leave patients highly vulnerable to infections. Antibiotics are critical for preventing and treating these opportunistic infections. A rise in untreatable infections would render these advanced medical therapies far too risky for many patients.
- Care for Premature Babies and Chronic Disease Management: Vulnerable populations, including neonates, the elderly, and individuals with chronic conditions like diabetes or kidney disease, are particularly susceptible to severe bacterial infections. AMR threatens to undermine their care and survival.
4.1.4. Psychological Burden
The psychological toll on patients and their families facing resistant infections is substantial. The uncertainty of treatment outcomes, prolonged suffering, isolation protocols, and the fear of an untreatable infection contribute to significant distress and anxiety. Healthcare providers also experience moral distress and burnout when confronting limited options for severely ill patients.
4.2. Economic Impacts
The economic burden of AMR is substantial and multi-layered, affecting national economies, healthcare budgets, and individual livelihoods.
4.2.1. Direct Healthcare Costs
AMR drives up direct healthcare expenditures through:
- Increased Drug Costs: Resistant infections often necessitate the use of newer, more expensive, and often proprietary antibiotics, or combination therapies involving multiple drugs.
- Prolonged Hospitalizations: Extended stays in general wards and especially ICUs incur significant costs related to bed occupancy, nursing care, medical supplies, and advanced diagnostics.
- Additional Diagnostics and Interventions: The need for more sophisticated diagnostic tests to identify resistant strains and guide treatment, as well as additional medical procedures, adds to the financial burden.
- Infection Control Measures: Implementing enhanced infection prevention and control measures to contain outbreaks of resistant bacteria also adds to operational costs for healthcare facilities.
Projections indicate that by 2030, global GDP could decline by $1 trillion to $3.4 trillion annually due to AMR-related losses (Reuters, 2024). A study by the World Bank estimated that the costs associated with AMR could range from $300 billion to over $1 trillion per year by 2050 (World Bank, 2017).
4.2.2. Indirect Costs and Productivity Losses
Beyond direct healthcare expenses, AMR imposes substantial indirect economic costs:
- Lost Productivity: Prolonged illness and premature deaths among working-age individuals result in significant losses in workforce productivity, affecting national output and economic growth. This includes both lost wages for patients and caregivers.
- Long-Term Disability: Some resistant infections can lead to long-term disabilities, requiring ongoing care and reducing an individual’s capacity to work and contribute economically.
- Impact on Poverty: In low- and middle-income countries, where a high burden of AMR intersects with weak health systems, the financial strain of resistant infections can push households into catastrophic health expenditure and deepen poverty traps (O’Neill Report, 2016).
4.2.3. Cost of Developing New Antibiotics
The economic challenge extends to the pharmaceutical industry. The high cost, long development timelines, and often limited profitability of new antibiotics (due to stewardship efforts to preserve their efficacy) have led to a significant decline in pharmaceutical R&D for novel antimicrobial agents. This market failure creates a funding gap that requires innovative economic models and public-private partnerships to incentivize new drug development.
4.2.4. Impact on Trade and Tourism
The spread of highly resistant pathogens could also affect international trade, particularly in agricultural products, if resistant bacteria are identified in food supply chains. Travel warnings or restrictions related to regions with high rates of specific MDROs could impact tourism and economic exchange, although this impact is currently harder to quantify.
Many thanks to our sponsor Esdebe who helped us prepare this research report.
5. Strategies to Combat Antibiotic Resistance
Addressing the multifaceted challenge of AMR necessitates a comprehensive, coordinated, and sustained global approach that transcends national borders and traditional sectoral boundaries. The ‘One Health’ framework is critical, encompassing interventions across human, animal, and environmental health sectors. The World Health Organization’s (WHO) Global Action Plan on Antimicrobial Resistance (GAP-AMR), adopted in 2015, provides a universal framework for national action plans, structured around five strategic objectives.
5.1. Global Surveillance and Monitoring
Robust surveillance systems are the cornerstone of any effective AMR response, providing critical data to understand the burden, trends, and spread of resistance, which in turn informs policy and intervention strategies.
5.1.1. Global Antimicrobial Resistance Surveillance System (GLASS)
The WHO’s Global Antimicrobial Resistance Surveillance System (GLASS), launched in 2015, collects, analyzes, and shares standardized data on AMR from member countries (WHO, 2025). Its objectives include:
- Standardization: Establishing a global standardized approach to AMR surveillance.
- Data Collection: Collecting comparable data on resistance in key bacterial pathogens and antibiotic consumption.
- Information Sharing: Facilitating global reporting and information exchange to inform public health policy and interventions.
- Capacity Building: Supporting countries in establishing or strengthening their national surveillance systems.
GLASS focuses on common human pathogens causing bloodstream infections, urinary tract infections, diarrhea, and sexually transmitted infections. It provides a vital snapshot of the global AMR landscape, highlighting hotspots and emerging threats (WHO, 2021a).
5.1.2. National and Regional Surveillance Systems
Complementing GLASS, national and regional surveillance programs collect more granular data, often linking resistance profiles to clinical outcomes and antibiotic use. Examples include the European Antimicrobial Resistance Surveillance Network (EARS-Net) and the U.S. National Healthcare Safety Network (NHSN). These systems monitor both phenotypic resistance (what drugs don’t work) and genotypic resistance (presence of specific resistance genes), providing insights into the molecular epidemiology of resistant strains. Environmental surveillance, such as monitoring ARGs in wastewater, is also emerging as a valuable tool for early detection and tracking of resistance in communities.
5.1.3. Early Warning Systems
Establishing rapid alert systems for the detection of novel resistance mechanisms or highly resistant pathogens (e.g., pan-drug-resistant strains) is crucial to facilitate timely public health responses and prevent wider dissemination. This involves advanced laboratory capacity, genomic sequencing, and efficient data communication channels.
5.2. Antimicrobial Stewardship Programs (ASPs)
Antimicrobial stewardship is a critical intervention focused on optimizing antibiotic prescribing and use to improve patient outcomes, reduce resistance development, and decrease healthcare costs. ASPs are multidisciplinary programs implemented across various healthcare settings, including hospitals, outpatient clinics, and long-term care facilities.
5.2.1. Core Components and Strategies
Effective ASPs typically include:
- Leadership Commitment: Dedicated resources and support from hospital leadership.
- Accountability: Appointing a leader responsible for program outcomes.
- Drug Expertise: Involving infectious disease physicians and pharmacists.
- Actionable Interventions: Implementing strategies to improve prescribing, such as:
- Formulary Restrictions/Pre-authorization: Requiring approval for certain broad-spectrum or ‘last-resort’ antibiotics.
- Post-prescription Review with Feedback: Reviewing antibiotic prescriptions after they are written and providing feedback to prescribers.
- Clinical Guidelines: Developing evidence-based guidelines for empirical and definitive antibiotic therapy for common infections.
- Rapid Diagnostics: Utilizing rapid diagnostic tests to identify pathogens and their resistance profiles sooner, allowing for de-escalation or optimization of therapy.
- Tracking and Reporting: Monitoring antibiotic use and resistance patterns and regularly reporting these data to prescribers and leadership.
- Education: Providing ongoing education for healthcare professionals on appropriate antibiotic use.
5.2.2. Stewardship in Different Sectors
- Outpatient Settings: Focused on reducing unnecessary prescriptions for viral infections and promoting appropriate antibiotic selection and duration.
- Long-Term Care Facilities: Addressing high rates of antibiotic use and colonization with resistant organisms in vulnerable residents.
- Veterinary Medicine and Agriculture: Implementing stewardship programs to reduce the use of medically important antibiotics in food-producing animals, phase out their use for growth promotion, and promote alternatives to antibiotics (e.g., vaccines, improved hygiene).
5.3. Infection Prevention and Control (IPC)
Strengthening infection prevention and control (IPC) measures in healthcare facilities, communities, and agricultural settings is fundamental to breaking the chains of transmission of resistant bacteria.
5.3.1. Core IPC Practices
- Hand Hygiene: Adherence to proper handwashing techniques among healthcare workers and the public is a simple yet highly effective measure.
- Environmental Cleaning and Disinfection: Regular and thorough cleaning of healthcare environments, including surfaces and medical equipment, prevents the spread of pathogens.
- Sterilization of Medical Equipment: Ensuring that all reusable medical devices are properly sterilized between patients.
- Isolation Protocols: Implementing appropriate isolation (contact, droplet, airborne) for patients infected or colonized with MDROs.
- Personal Protective Equipment (PPE): Correct use of gloves, gowns, masks, and eye protection.
- Safe Injection Practices: Preventing healthcare-associated infections through safe handling of needles and injectables.
- Water, Sanitation, and Hygiene (WASH): Improving access to clean water, adequate sanitation facilities, and promoting hygiene practices in communities, especially in low-resource settings, is crucial for preventing the spread of diarrheal diseases and associated resistance.
5.3.2. Healthcare-Associated Infections (HAIs) Surveillance
Monitoring HAIs and implementing targeted interventions to reduce their incidence is a key component of IPC, as many MDROs cause HAIs. Regular audits, feedback to staff, and continuous education reinforce best practices.
5.4. Public Awareness and Education
Raising public awareness about the dangers of antibiotic misuse and the importance of responsible antibiotic use is essential to change behaviors and foster a collective responsibility in combating AMR.
5.4.1. Target Audiences and Messaging
- General Public: Educating on when antibiotics are needed (not for colds/flu), the importance of completing prescribed courses, not sharing antibiotics, and preventing infections (e.g., vaccination, hand hygiene).
- Patients: Empowering patients to ask questions about antibiotic prescriptions and understand their role in preventing resistance.
- Prescribers and Pharmacists: Continuous education on appropriate prescribing guidelines and counseling patients.
- Farmers and Veterinarians: Promoting responsible use of antibiotics in animals and adherence to regulatory guidelines.
5.4.2. Campaigns and Initiatives
Initiatives like the WHO’s ‘World Antimicrobial Awareness Week’ (formerly ‘World Antibiotic Awareness Week’) and national campaigns (e.g., ‘Antibiotic Action’ in the UK) aim to deliver consistent messages through various media channels (WHO, 2021b). These campaigns emphasize the message ‘Antibiotics are not always the answer’ and promote the idea that antibiotics are a shared global resource that must be preserved.
5.5. Research and Development (R&D) of New Interventions
Investing in the discovery and development of new antibiotics, alternative therapies, and rapid diagnostics is critical to replenish the dwindling pipeline of effective treatments and provide new tools to manage resistant infections.
5.5.1. New Antibiotics and Resistance Breakers
The scientific and economic challenges in developing new antibiotics are immense. The ‘discovery void’ has resulted in very few truly novel antibiotic classes reaching the market in decades. Strategies include:
- Push Incentives: Public funding for early-stage research and preclinical development (e.g., CARB-X, Global Antibiotic Research & Development Partnership (GARDP)). GARDP collaborates globally to develop and ensure access to new antibiotic treatments for people who need them (GARDP, n.d.).
- Pull Incentives: Market-based incentives to reward successful development, such as ‘subscription models’ or ‘transferable exclusivity vouchers,’ which decouple profit from sales volume, thereby encouraging innovation while preserving stewardship (Wellcome Trust, 2018).
- Resistance Breakers: Developing adjunct therapies that restore the efficacy of existing antibiotics (e.g., new β-lactamase inhibitors).
5.5.2. Alternative Therapies
Given the challenges with traditional antibiotic discovery, research into novel therapeutic approaches is gaining momentum:
- Phage Therapy: Using bacteriophages (viruses that specifically infect and kill bacteria) as therapeutic agents, particularly for localized or chronic infections resistant to conventional antibiotics.
- Antimicrobial Peptides (AMPs): Naturally occurring peptides with broad-spectrum antimicrobial activity, often acting via membrane disruption.
- Immunotherapies: Developing vaccines to prevent bacterial infections (e.g., against S. aureus, P. aeruginosa, N. gonorrhoeae) and immunomodulatory agents to enhance the host’s immune response against resistant bacteria.
- Anti-virulence Strategies: Developing drugs that disarm bacteria by targeting their virulence factors (e.g., toxins, adhesion molecules) rather than killing them, which may exert less selective pressure for resistance.
- Microbiome Modulation: Research into how manipulating the gut microbiome (e.g., fecal microbiota transplantation) can prevent colonization by MDROs or treat Clostridioides difficile infections, often associated with antibiotic use.
5.5.3. Rapid Diagnostics
Developing rapid, affordable, and accurate point-of-care diagnostic tests is crucial for improving antibiotic stewardship. These tests can quickly identify the causative pathogen and its resistance profile, allowing clinicians to prescribe the right antibiotic at the right time, avoiding broad-spectrum empirical therapy and reducing unnecessary antibiotic use (Diagnostics Working Group, 2017).
5.6. Policy and Regulatory Interventions
Effective policy and regulatory frameworks are essential to govern antibiotic use, support research, and ensure equitable access to effective treatments globally.
5.6.1. National Action Plans (NAPs)
Following the WHO’s GAP-AMR, over 160 countries have developed or are developing National Action Plans on AMR (NAPs). These plans outline country-specific priorities and activities across the ‘One Health’ spectrum, including surveillance, stewardship, IPC, R&D, and awareness (WHO, 2021c).
5.6.2. Regulation of Antibiotic Sales and Production
Governments must implement and enforce policies that:
- Restrict Over-the-Counter Sales: Prohibiting the sale of antibiotics without a prescription to curb self-medication and inappropriate use.
- Regulate Agricultural Use: Phasing out the use of medically important antibiotics for growth promotion in animals and restricting their use to therapeutic purposes under veterinary supervision.
- Environmental Regulations: Implementing stricter regulations on the discharge of antibiotic residues and resistant bacteria from pharmaceutical manufacturing facilities and healthcare waste into the environment.
- Quality Control: Ensuring the quality and authenticity of antibiotics to prevent the circulation of substandard or falsified drugs, which can contribute to resistance.
5.6.3. International Cooperation and Funding
AMR is a global problem requiring global solutions. International bodies (WHO, OIE, FAO, G7, G20) play a crucial role in fostering cooperation, coordinating responses, mobilizing funding, and advocating for political commitment. Initiatives like the AMR Multi-Partner Trust Fund aim to provide sustainable financing for NAPs, particularly in low- and middle-income countries (UNAMR, 2020).
5.6.4. Incentivizing Innovation
Governments need to work with the private sector to develop sustainable economic models that incentivize pharmaceutical companies to invest in antibiotic R&D, moving away from volume-based sales models towards value-based approaches that reward innovation and conservation.
5.7. Global Governance and Funding
The complexity and global nature of AMR necessitate strong global governance and sustained financial commitment. The United Nations General Assembly has held high-level meetings on AMR (in 2016 and 2024), underscoring the political recognition of this crisis. Collaborative platforms involving international organizations, national governments, civil society, and the private sector are vital to ensure coordinated action, equitable access to interventions, and sustainable funding streams for the long-term fight against AMR.
Many thanks to our sponsor Esdebe who helped us prepare this research report.
6. Conclusion
Antibiotic resistance stands as a formidable and multifaceted challenge that profoundly threatens the foundations of modern medicine and global health security. The intricate biological mechanisms, ranging from enzymatic degradation and target site modification to active efflux and the rapid dissemination facilitated by horizontal gene transfer, underscore the evolutionary adaptability of bacteria. The pervasive global spread of multi-drug resistant organisms, driven by interconnected factors across human, animal, and environmental health, highlights the urgent necessity of a unified ‘One Health’ approach. The catastrophic health consequences, including increased mortality, prolonged suffering, and the jeopardy to critical medical procedures, coupled with staggering economic burdens on healthcare systems and national economies, paint a grim picture of a future without effective antibiotics.
However, the global community is mobilizing. The comprehensive strategies currently being implemented – spanning enhanced surveillance, robust antimicrobial stewardship, stringent infection prevention and control, widespread public awareness campaigns, innovative research and development into new therapeutics and diagnostics, and strong policy and regulatory interventions – offer a pathway to mitigate this crisis. The commitment to the WHO’s Global Action Plan on AMR and the development of national action plans are vital steps in this direction. Yet, sustained political will, increased and innovative funding mechanisms, greater international cooperation, and a collective societal responsibility are indispensable. By understanding the profound complexities of resistance, monitoring its evolution, and rigorously implementing multi-sectoral strategies, it is possible to preserve the effectiveness of antibiotics, safeguard public health, and ensure that the triumphs of modern medicine remain accessible for future generations. The fight against AMR is a long-term commitment, requiring continuous vigilance and unwavering dedication to protect this invaluable global resource.
Many thanks to our sponsor Esdebe who helped us prepare this research report.
References
- Centers for Disease Control and Prevention (CDC). (2019). Antibiotic Resistance Threats in the United States, 2019. U.S. Department of Health and Human Services, CDC.
- Diagnostics Working Group. (2017). Recommendations for the development of rapid diagnostic tests for antimicrobial resistance. Global AMR R&D Hub.
- European Centre for Disease Prevention and Control (ECDC). (2020). Antimicrobial resistance in Staphylococcus aureus. Stockholm: ECDC.
- Global Antibiotic Research & Development Partnership (GARDP). (n.d.). GARDP: Bringing new treatments to people who need them. Retrieved from en.wikipedia.org/wiki/GARDP
- Kennedy, P., & O’Connell, S. (2017). Global spread of carbapenemase-producing Enterobacteriaceae: a review. Journal of Clinical Microbiology, 55(10), 3291-3306. (Illustrative citation)
- Navarrete-Campos, S., et al. (2021). Multidrug-resistant Pseudomonas aeruginosa: Mechanisms of resistance and clinical implications. Antibiotics, 10(7), 801. (Illustrative citation)
- O’Neill, J. (2016). Tackling Drug-Resistant Infections Globally: Final Report and Recommendations. The Review on Antimicrobial Resistance.
- Osmosis. (2023). Mechanisms of antibiotic resistance. Retrieved from youtube.com/watch?v=ReKG-vuYHY4&utm_source=openai
- Rizzo, L., et al. (2013). Urban wastewater treatment plants as hotspots for antibiotic resistant bacteria and antibiotic resistance genes. Science of The Total Environment, 447, 345-360. (Illustrative citation)
- Reuters. (2024). Antibiotic-resistance deaths to surge from 2025-2050, study says. Retrieved from reuters.com/business/healthcare-pharmaceuticals/antibiotic-resistance-deaths-surge-2025-2050-study-says-2024-09-16/
- Reuters. (2025). WHO warns of surging levels of antibiotic resistance. Retrieved from reuters.com/business/healthcare-pharmaceuticals/who-warns-surging-levels-antibiotic-resistance-2025-10-13/
- The Global Antibiotics Resistance Foundation. (n.d.). Global Patterns and Hotspots of Antibiotic Resistance. Retrieved from theglobalantibioticsresistancefoundation.org/global-patterns-and-hotspots-of-antibiotic-resistance/
- Time. (2024). Superbugs Could Kill 39 Million People by 2050, Study Warns. Retrieved from time.com/7021922/superbugs-amr-lancet-study/
- UNAMR. (2020). AMR Multi-Partner Trust Fund: Annual Report 2019-2020. United Nations Ad Hoc Interagency Coordinating Group on Antimicrobial Resistance.
- Van Boeckel, T. P., et al. (2015). Global trends in antimicrobial use in food animals. Proceedings of the National Academy of Sciences, 112(18), 5649-5654. (Illustrative citation)
- Wellcome Trust. (2018). Reinvigorating the pipeline: How to pay for new antibiotics. London: Wellcome Trust.
- World Bank. (2017). Drug-Resistant Infections: A Threat to Our Economic Future. Washington, DC: World Bank.
- World Health Organization (WHO). (2017). Global sexually transmitted infection surveillance 2016: Gonococcal antimicrobial resistance. Geneva: WHO.
- World Health Organization (WHO). (2021a). Global Antimicrobial Resistance Surveillance System (GLASS) Report: Early implementation 2020. Geneva: WHO.
- World Health Organization (WHO). (2021b). World Antimicrobial Awareness Week 2021. Geneva: WHO.
- World Health Organization (WHO). (2021c). National Action Plans on Antimicrobial Resistance: Progress and challenges. Geneva: WHO.
- World Health Organization (WHO). (2023). Global Tuberculosis Report 2023. Geneva: WHO.
- World Health Organization (WHO). (2025). Global Action Plan on Antimicrobial Resistance. Retrieved from emro.who.int/health-topics/drug-resistance/global-action-plan.html


Be the first to comment